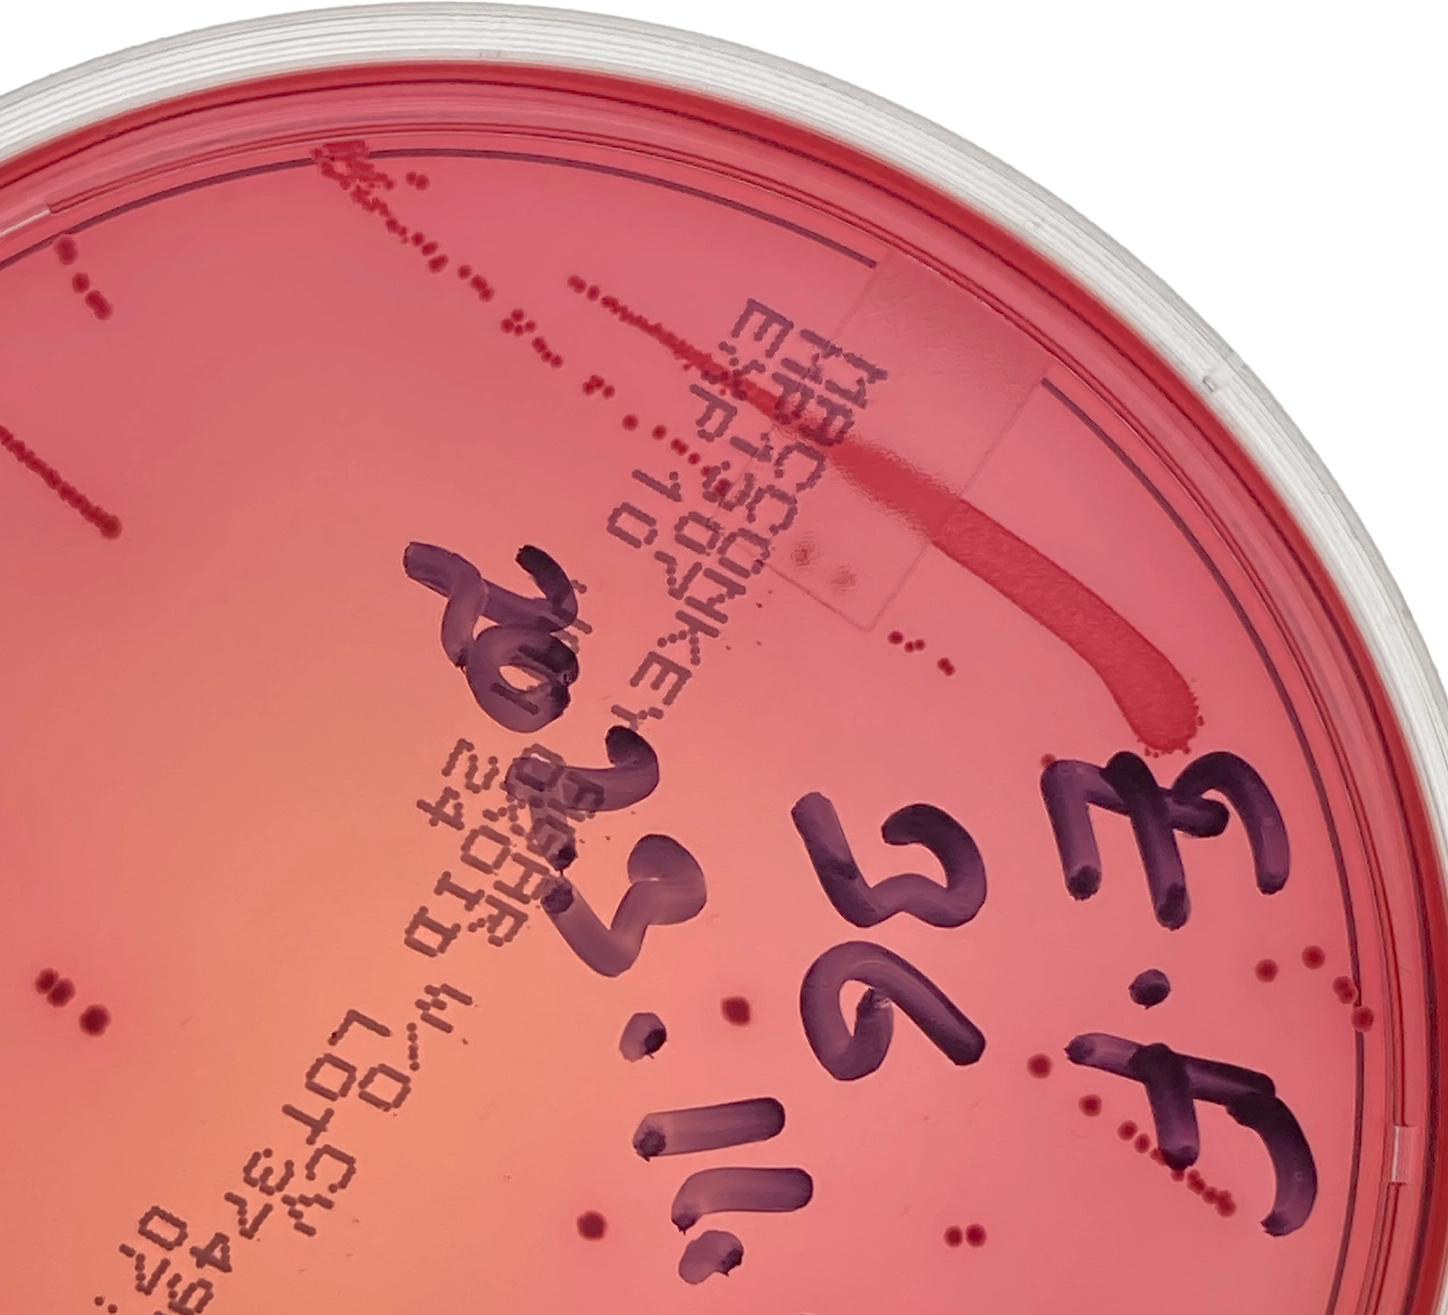

Expertise
Scientific roots,
new ground.
LifeLore Pathways is part of the Proventus ecosystem.
Proventus Bioscience focuses on large-scale industrial applications, developing biosolutions through a full-service CDMO model covering research, development, and production.
LifeLore Pathways brings the same scientific expertise to human health, animal health, and environmental biotech.
Expertise
What we do
We accelerate the transition to sustainable biologics, enzymes, and proteins through advanced microbial science, smart automation, and strong quality systems.
Our lab is GMP-compatible and tailored for small-batch production, ideal for testing, optimizing, and scaling new microbial solutions.